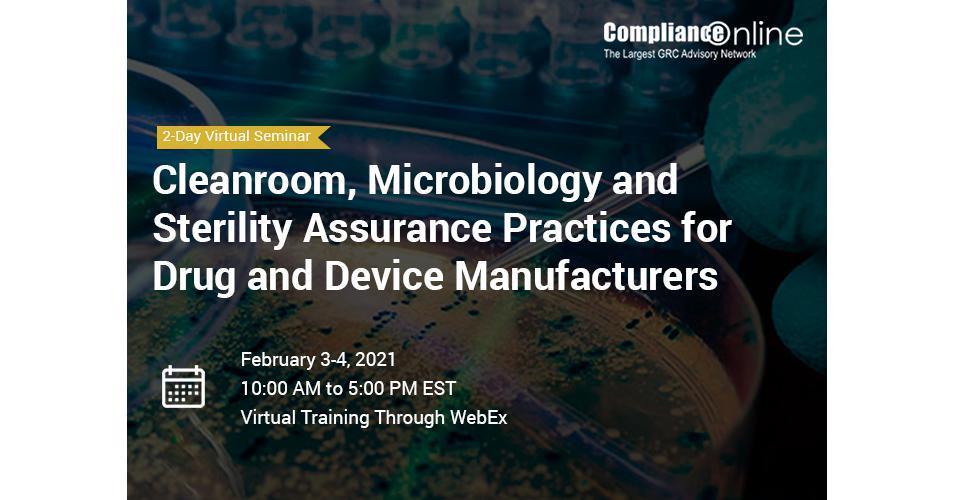

2-Day ComplianceOnline Seminar: Cleanroom, Microbiology & Sterility Assurance Practices for Drug & Device Manufacturers

Cleanroom, Microbiology and Sterility Assurance Practices
This workshop will explain Cleanroom Regulations, Design Requirements, Validation/Qualification, Environmental Monitoring Program & Excursion investigations.
SAN JOSE, CA, USA, January 27, 2021 /EINPresswire.com / -- Learn about various key elements of sterility assurance and contamination control such as Cleanroom Regulations, Classification, Sources and types of particles, Design Requirements, Validation/Qualification, Operations, Environmental Monitoring Program requirements, Excursion investigations, DataTrending, Microbiological processes/methodology, Cleanroom cleaning/disinfection. The types of micro-organisms, typical mitigation steps in ensuring an effective contamination control through Personnel Training (Aseptic Practices, Cleanroom Behavior and Contamination Control Procedures),Gowning Controls, Personnel Training, Cleanroom Trafficking (Cleanroom Personnel Material, Product and Equipment Transfer Practices and Training (Entry and Exit Policy), Cleanroom Gowning, Contamination Control, Cleaning and Disinfection Program and the Basics of Sterilization Processes- Physical and Chemical Processes will also be discussed. The various regulatory bodies' requirements such as 21 CFR Part 211 (mostly relevant 211.113 'Control of microbiological contamination', ISO 14644 (Various Parts), FDA Guidance for Industry: Sterile Drug Products Produced By Aseptic Processing - Current Good Manufacturing Practice') amongst others and the criticality of aseptic processing and other key contamination control evaluators during the manufacture and testing of products are important to the quality determination and release of the finished manufactured products.
The seminar will consist of two (2) Parts for a total of 6 Modules.
There are seven (7) key topics that will be discussed on Day 1 and Day 2 of the Seminar are as follows:
- Cleanroom Regulations, Classifications, Basic Background and Design Considerations
- Cleanroom Qualification, Cleaning Validation (IOQ/PQ), Routine Monitoring and Excursion Investigation
- Environmental Monitoring Program (Monitoring, Excursion Investigation and Trending of Data)
- Personnel Training (Aseptic Practices, Cleanroom Behavior and Contamination Control Procedures)
- Cleanroom Trafficking (Cleanroom Personnel Material, Product and Equipment Transfer Practices and Training (Entry and Exit Policy)
- Cleanroom Gowning, Contamination Control, Cleaning and Disinfection Program
- Basics of Sterilization Processes- Physical and Chemical Processes
Learning Objectives:
- Discuss Cleanroom Classification, Regulations and Guidelines
- Summarize how to Perform Cleanroom Design, Validation/Qualification, Operation, Environmental Monitoring Program and ensuring a state of control
- Describe Aseptic Practices, Personnel Health Practices, Gowning and Trafficking Patterns in a Cleanroom
- Establish and describe the Requirements of Cleanroom Cleaning/Disinfection and Contamination Control Practices
- Summarize various Sterilization Processes, Advantages and Disadvantages –both Physical and Chemical
- Describe the Sterilization Processes and Controls
For more information or to register for this seminar, please click here .
Virtual Training Through WebEx
Date: January 28-29, 2021 (10:00 AM - 5:00 PM EST)
Register by phone: Please call our customer service specialists at +1-888-717-2436 or email to
Who will Benefit:
This training will benefit those involved in the manufacturing, processing, testing and release of sterile and non-sterile products. It will provide the attendee an understanding of the basic concept of microbiology, microbiological and contamination control practices, cleanroom design, routine testing, qualification/validation and use of cleanrooms as well as the typical sterilization processes (Physical and Chemical) within various industries such as the Pharmaceutical, Biotechnology, Drug, Biologics, Medical Device and In-vitro Diagnostics Product Manufacturing Industries, especially personnel and management in:
. Quality Assurance
. Quality Control
. Manufacturing
. Validation
. Supplier Quality Assurance
. Regulatory Affairs
. Shipping and Receiving
. Facility and Maintenance
. Engineering
. Materials Management
. Analysts
. Analytical Chemists
. All levels of management
. Microbiologists
About the Speaker:
Charity Ogunsanya, is the CEO and founder of Pharmabiodevice Consulting LLC. Ms. Ogunsanya has over 23 years of extensive practical and management experience in various Fortune 100 pharmaceutical, biotechnology, biologics, cell therapy, diagnostics, research and development, radio-pharmaceutical, Contract Manufacturing Organization (CMO) and medical device/IVD companies.
She has been a much sought after SME to assume key roles specifically related to remediation and difficult quality and compliance related deficiencies associated with FDA's Consent Decree, FDA's Warning Letters and other regulatory bodies' inspectional findings. Her remediation work has constantly resulted in several successful national and international regulatory bodies' inspections, re-inspections and new product approvals.
About ComplianceOnline.com:
ComplianceOnline is a leading provider of regulatory compliance training programs for companies and professionals in regulated industries. ComplianceOnline has successfully trained over 55,000 professionals from 15,000 companies to comply with the requirements of regulatory agencies. ComplianceOnline is headquartered in Palo Alto, California, and can be reached at [...] . ComplianceOnline is a MetricStream portal. MetricStream ([...] ) is a market leader in Enterprise-wide Governance, Risk, Compliance (GRC), and Quality Management Solutions for global corporations.
For more information on ComplianceOnline or to browse through our trainings, please visit our website
Priyabrata Sahoo
ComplianceOnline
+1 888-717-2436
email us here
Visit us on social media:
Facebook
Twitter
LinkedIn

Legal Disclaimer:
MENAFN provides the
information “as is” without warranty of any kind. We do not accept
any responsibility or liability for the accuracy, content, images,
videos, licenses, completeness, legality, or reliability of the information
contained in this article. If you have any complaints or copyright
issues related to this article, kindly contact the provider above.
Most popular stories
Market Research

- Xmoney Launches $XMN On Sui, Expands Listings Across Global Exchanges
- Ozzy Tyres Grows Their Monsta Terrain Gripper Tyres Performing In Australian Summers
- Cregis And Kucoin Host Institutional Web3 Forum Discussing Industry Trends And Opportunities
- Superiorstar Prosperity Group Russell Hawthorne Highlights New Machine Learning Risk Framework
- Dexari Unveils $1M Cash Prize Trading Competition
- Xdata Group Named Among The Top 66 Saas Innovators In Techround's 2025 List

Comments
No comment